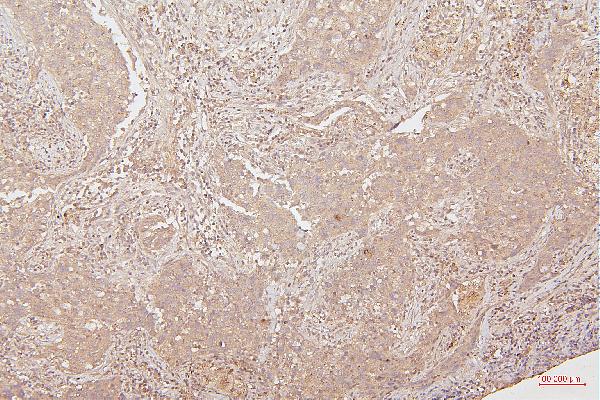

Anti-HMGB1 Antibody Picoband™ (monoclonal, 5H3)
- SPECIFICATION
- CITATIONS
- PROTOCOLS
- BACKGROUND

Application
| WB, IHC, FC |
|---|---|
| Primary Accession | P09429 |
| Host | Mouse |
| Isotype | Mouse IgG2b |
| Reactivity | Rat, Human, Mouse, Monkey |
| Clonality | Monoclonal |
| Format | Lyophilized |
| Description | Anti-HMGB1 Antibody Picoband™ (monoclonal, 5H3) . Tested in Flow Cytometry, IHC, WB applications. This antibody reacts with Human, Monkey, Mouse, Rat. |
| Reconstitution | Add 0.2ml of distilled water will yield a concentration of 500 µg/ml. |
| Gene ID | 3146 |
|---|---|
| Other Names | High mobility group protein B1, High mobility group protein 1, HMG-1, HMGB1 (HGNC:4983), HMG1 |
| Calculated MW | 25 kDa |
| Application Details | Western blot, 0.1-0.5 µg/ml, Human, Mouse, Rat, Monkey Immunohistochemistry (Paraffin-embedded Section), 0.5-1 µg/ml, Human, Mouse, Rat, By Heat Flow Cytometry, 1-3 µg/1x10^6 cells, Human |
| Subcellular Localization | Nucleus. Endosome. Secreted. Cell membrane. Peripheral membrane protein. Extracellular side. Chromosome. Cytoplasm. Endoplasmic reticulum-Golgi intermediate compartment. |
| Tissue Specificity | Ubiquituous. Expressed in platelets. |
| Contents | Each vial contains 4mg Trehalose, 0.9mg NaCl, 0.2mg Na2HPO4, 0.05mg NaN3. |
| Clone Names | Clone: 5H3 |
| Immunogen | A synthetic peptide corresponding to a sequence at the C-terminus of human HMGB1, identical to the related mouse and rat sequences. |
| Cross Reactivity | No cross-reactivity with other proteins. |
| Storage | Store at -20˚C for one year from date of receipt. After reconstitution, at 4˚C for one month. It can also be aliquotted and stored frozen at -20˚C for six months. Avoid repeated freeze-thaw cycles. |
| Name | HMGB1 (HGNC:4983) |
|---|---|
| Synonyms | HMG1 |
| Function | Multifunctional redox sensitive protein with various roles in different cellular compartments. In the nucleus is one of the major chromatin-associated non-histone proteins and acts as a DNA chaperone involved in replication, transcription, chromatin remodeling, V(D)J recombination, DNA repair and genome stability (PubMed:33147444). Proposed to be an universal biosensor for nucleic acids. Promotes host inflammatory response to sterile and infectious signals and is involved in the coordination and integration of innate and adaptive immune responses. In the cytoplasm functions as a sensor and/or chaperone for immunogenic nucleic acids implicating the activation of TLR9-mediated immune responses, and mediates autophagy. Acts as a danger-associated molecular pattern (DAMP) molecule that amplifies immune responses during tissue injury (PubMed:27362237). Released to the extracellular environment can bind DNA, nucleosomes, IL-1 beta, CXCL12, AGER isoform 2/sRAGE, lipopolysaccharide (LPS) and lipoteichoic acid (LTA), and activates cells through engagement of multiple surface receptors (PubMed:34743181). In the extracellular compartment fully reduced HMGB1 (released by necrosis) acts as a chemokine, disulfide HMGB1 (actively secreted) as a cytokine, and sulfonyl HMGB1 (released from apoptotic cells) promotes immunological tolerance (PubMed:23446148, PubMed:23519706, PubMed:23994764, PubMed:25048472). Has proangiogdenic activity (By similarity). May be involved in platelet activation (By similarity). Binds to phosphatidylserine and phosphatidylethanolamide (By similarity). Bound to RAGE mediates signaling for neuronal outgrowth (By similarity). May play a role in accumulation of expanded polyglutamine (polyQ) proteins such as huntingtin (HTT) or TBP (PubMed:23303669, PubMed:25549101). |
| Cellular Location | Nucleus. Chromosome {ECO:0000250|UniProtKB:P10103, ECO:0000250|UniProtKB:P63159, ECO:0000305}. Cytoplasm. Secreted {ECO:0000250|UniProtKB:P63158, ECO:0000269|PubMed:12231511, ECO:0000269|PubMed:14532127, ECO:0000269|PubMed:15944249, ECO:0000269|PubMed:19811284, ECO:0000269|PubMed:22869893, ECO:0000269|PubMed:33147444}. Cell membrane {ECO:0000250|UniProtKB:P63158, ECO:0000250|UniProtKB:P63159, ECO:0000269|PubMed:11154118}; Peripheral membrane protein {ECO:0000250|UniProtKB:P63158, ECO:0000250|UniProtKB:P63159, ECO:0000269|PubMed:11154118}; Extracellular side {ECO:0000250|UniProtKB:P63158, ECO:0000250|UniProtKB:P63159, ECO:0000269|PubMed:11154118}. Endosome {ECO:0000250|UniProtKB:P63158} Endoplasmic reticulum-Golgi intermediate compartment {ECO:0000250|UniProtKB:P63158}. Note=In basal state predominantly nuclear. Shuttles between the cytoplasm and the nucleus (PubMed:12231511, PubMed:17114460). Translocates from the nucleus to the cytoplasm upon autophagy stimulation (PubMed:20819940). Release from macrophages in the extracellular milieu requires the activation of NLRC4 or NLRP3 inflammasomes (By similarity). Passively released to the extracellular milieu from necrotic cells by diffusion, involving the fully reduced HGMB1 which subsequently gets oxidized (PubMed:19811284) Also released from apoptotic cells (PubMed:16855214, PubMed:18631454) Active secretion from a variety of immune and non-immune cells such as macrophages, monocytes, neutrophils, dendritic cells and natural killer cells in response to various stimuli such as LPS and cytokines involves a nonconventional secretory process via secretory lysosomes (PubMed:12231511, PubMed:14532127, PubMed:15944249). Secreted by plasma cells in response to LPS (By similarity). Found on the surface of activated platelets (PubMed:11154118). An increased chromatin association is observed when associated with the adenovirus protein pVII (PubMed:27362237). {ECO:0000250|UniProtKB:P63158, ECO:0000269|PubMed:11154118, ECO:0000269|PubMed:12231511, ECO:0000269|PubMed:14532127, ECO:0000269|PubMed:15944249, ECO:0000269|PubMed:16855214, ECO:0000269|PubMed:17114460, ECO:0000269|PubMed:18631454, ECO:0000269|PubMed:19811284, ECO:0000269|PubMed:20819940, ECO:0000269|PubMed:27362237, ECO:0000305|PubMed:20123072} |
| Tissue Location | Ubiquitous. Expressed in platelets (PubMed:11154118). |

Thousands of laboratories across the world have published research that depended on the performance of antibodies from Abcepta to advance their research. Check out links to articles that cite our products in major peer-reviewed journals, organized by research category.
info@abcepta.com, and receive a free "I Love Antibodies" mug.
Provided below are standard protocols that you may find useful for product applications.
Background
High mobility group box 1 protein, also known as high-mobility group protein 1 (HMG-1) and amphoterin, is a protein that in humans is encoded by the HMGB1 gene. This gene encodes a protein that belongs to the High Mobility Group-box superfamily. The encoded non-histone, nuclear DNA-binding protein regulates transcription, and is involved in organization of DNA. This protein plays a role in several cellular processes, including inflammation, cell differentiation and tumor cell migration. Multiple pseudogenes of this gene have been identified. Alternative splicing results in multiple transcript variants that encode the same protein.
If you have used an Abcepta product and would like to share how it has performed, please click on the "Submit Review" button and provide the requested information. Our staff will examine and post your review and contact you if needed.
If you have any additional inquiries please email technical services at tech@abcepta.com.





Foundational characteristics of cancer include proliferation, angiogenesis, migration, evasion of apoptosis, and cellular immortality. Find key markers for these cellular processes and antibodies to detect them.
The SUMOplot™ Analysis Program predicts and scores sumoylation sites in your protein. SUMOylation is a post-translational modification involved in various cellular processes, such as nuclear-cytosolic transport, transcriptional regulation, apoptosis, protein stability, response to stress, and progression through the cell cycle.
The Autophagy Receptor Motif Plotter predicts and scores autophagy receptor binding sites in your protein. Identifying proteins connected to this pathway is critical to understanding the role of autophagy in physiological as well as pathological processes such as development, differentiation, neurodegenerative diseases, stress, infection, and cancer.